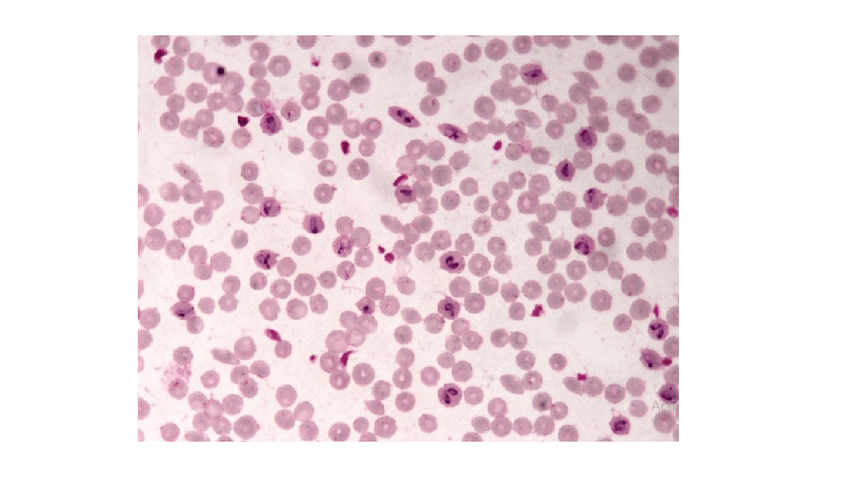

Parasitología
He publicado nuevos examenes de 2º Parasitología: Tipo-TEST-Platelmintos.pdf
He publicado nuevos apuntes de 2º Parasitología: 1er-Parcial-parasitologia-2526.pdf
He publicado nuevos apuntes de 2º Parasitología: 2o-parcial-parasitologia-2526.pdf
He publicado nuevos examenes de 2º Parasitología: Tipo-TEST-Nematodos-T20-T24.pdf
He publicado nuevos examenes de 2º Parasitología: PROTISTAS-Tipo-Test.pdf
He publicado nuevos practicas de 2º Parasitología: PRACTICA-K--NEMATODOS.pdf
He publicado nuevos apuntes de 2º Parasitología: PARASITOLOGIA-2o-parcial.pdf
He publicado nuevos apuntes de 2º Parasitología: PARASITOLOGIA-1er-parcial.pdf
He publicado nuevos apuntes de 2º Parasitología: TEMA-30.-Acantocephala.-Pentastomida.pdf
He publicado nuevos practicas de 2º Parasitología: Informe-practica-I.pdf
apuntes
-
Parasitología 2º parcial
He publicado nuevos apuntes de 2º Parasitología: Parasitología 2º parcial
apuntes
-
Practico
He publicado nuevos apuntes de 2º Parasitología: Practico
apuntes
-
PARASITOLOGÍA
He publicado nuevos apuntes de 2º Parasitología: PARASITOLOGÍA
He publicado nuevos apuntes de 2º Parasitología: Dicrocoelium-dendriticum-CB-con-IMAGENES.pdf
He publicado nuevos apuntes de 2º Parasitología: PROTOZOOS-parasitologia-primer-parcial.pdf
He publicado nuevos apuntes de 2º Parasitología: PLATELMINTOS-parasitologia-primer-parcial.pdf
apuntes
-
ESQUEMAS PRIMER PARCIAL
He publicado nuevos apuntes de 2º Parasitología: ESQUEMAS PRIMER PARCIAL
He publicado nuevos apuntes de 2º Parasitología: Apuntes-Parasito-2o-PARCIAL-2024.pdf
He publicado nuevos apuntes de 2º Parasitología: Parasitologia-apuntes-temas-1-11.pdf
He publicado nuevos apuntes de 2º Parasitología: Parasitologia-tema-11.pdf
He publicado nuevos apuntes de 2º Parasitología: Parasitologia-tema-10.pdf
He publicado nuevos apuntes de 2º Parasitología: Parasitologia-tema-9.pdf
He publicado nuevos apuntes de 2º Parasitología: Parasitologia-tema-8.pdf
He publicado nuevos apuntes de 2º Parasitología: Parasitologia-tema-7.pdf
He publicado nuevos apuntes de 2º Parasitología: Parasitologia-tema-6.pdf
He publicado nuevos apuntes de 2º Parasitología: Parasitologia-apuntes-temas-1-5.pdf
He publicado nuevos practicas de 2º Parasitología: Informe-practica-E.pdf
He publicado nuevos examenes de 2º Parasitología: GLOBAL-EXTRAORDINARIA-2025.pdf
He publicado nuevos apuntes de 2º Parasitología: Apuntes-segundo-parcial-parasitologia-22.pdf
He publicado nuevos apuntes de 2º Parasitología: Apuntes-segundo-parcial-parasitologia-12.pdf
He publicado nuevos apuntes de 2º Parasitología: Apuntes-segundo-parcial-parasitologia.pdf
He publicado nuevos apuntes de 2º Parasitología: tabla-garrapatas-durasblandas.pdf
He publicado nuevos apuntes de 2º Parasitología: apuntes-primer-parcial.pdf
He publicado nuevos practicas de 2º Parasitología: Trabajo-de-Practica-J.pdf
son maás de 200 preguntas que engloban el examen final
He publicado nuevos practicas de 2º Parasitología: parasitologia-practico.pdf
He publicado nuevos apuntes de 2º Parasitología: Tabla-segundo-parcial.pdf
He publicado nuevos apuntes de 2º Parasitología: Tabla-trematodos-y-cestodos-21.pdf
He publicado nuevos apuntes de 2º Parasitología: Solucion-imagenes-REPASO-T8-Clase-Kinetoplastea.pdf
He publicado nuevos apuntes de 2º Parasitología: Imagenes-REPASO-T8-Clase-Kinetoplastea.pdf
He publicado nuevos apuntes de 2º Parasitología: Tabla-cb-de-protistas.pdf
He publicado nuevos apuntes de 2º Parasitología: Solucion-REPASO-T11-Apicomplejos-II.pdf
He publicado nuevos practicas de 2º Parasitología: Imagenes-de-REPASO-T11-Apicomplejos-II.pdf
He publicado nuevos practicas de 2º Parasitología: SOLUCION-IMAGENES-de-PRACTICAS-TEMA-10.pdf
He publicado nuevos practicas de 2º Parasitología: IMAGENES-de-REPASO-T1O-(Apicomplejos I).pdf
He publicado nuevos practicas de 2º Parasitología: FASCIOLA-HEPATICA-Ciclo-Biológico-con-imágenes.pdf
apuntes
-
Apuntes examen practico 2025
He publicado nuevos apuntes de 2º Parasitología: Apuntes examen practico 2025
He publicado nuevos apuntes de 2º Parasitología: Ciclos-biologicos-TEMA-10.pdf
He publicado nuevos apuntes de 2º Parasitología: TAENIA-SOLIUM-Ciclo-Biologico Esquemático.pdf